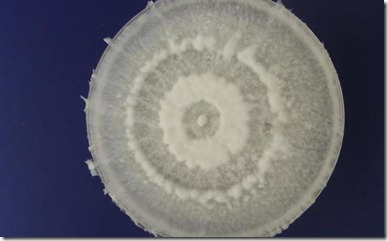
foto-galeria-materia-620-p5

20 de fevereiro de 2012
Por: Paulo Yokota | Seção: Cultura, Editoriais, Notícias, webtown | Tags: boa assessoria de imprensa, destaque na imprensa, Gaviões da Fiel em São Paulo, Sabrina Sato, Suingueira de Noel da Vila Isabel no Rio de Janeiro
Existem personalidades da televisão brasileira que contam com uma eficiente assessoria de imprensa, conseguindo grande destaque na mídia em geral. Sabrina Sato mereceu uma boa foto de primeira página da Folha de S.Paulo, bem como apareceu também com menos destaque na primeira página de O Estado de S.Paulo, além de figurar com uma ótima entrevista no site da Ig.
No Carnaval de São Paulo, ela desfilou como a madrinha da bateria da Gaviões da Fiel que homenageava o ex-presidente Lula da Silva, e no Rio de Janeiro deve fazer o mesmo com a bateria do Suingueira de Noel, da Vila Isabel, mostrando que, ao lado de sua competência no samba, conta com uma boa cobertura de importantes órgãos de comunicação social.

Sabrina Sato no desfile da Gaviões da Fiel. Foto: Futura Press/AE
Leia o restante desse texto »
20 de fevereiro de 2012
Por: Paulo Yokota | Seção: Cultura, Economia, Editoriais, Notícias, Política, webtown | Tags: Applied and Environmental Microbiology, artigo de Alexandre Gonçalves, O Estado de S.Paulo, trabalho publicado pelos estudantes de Yale
Um interessante artigo foi publicado por Alexandre Gonçalves no O Estado de S.Paulo, com base no trabalho científico publicado no Applied and Environmental Microbiology pelos alunos de graduação da Universidade de Yale, referindo-se a um fungo amazônico que degrada plásticos em condições semelhantes às de aterro. Como os cientistas norte-americanos identificaram mais de 50 microorganismos que consumiram o petróleo derramado no Golfo do México, é muito provável que estes que degradam plásticos também existam, com grandes potencialidades de aplicação.
Segundo o artigo, duas cepas de Pestalotiopsis microcraspora mostraram enorme potencialidade de degradação dos plásticos de poliretano. O estudante Jonathan Russell identificou e segregou a enzima secretada pelo fungo responsável pelo enfraquecimento das ligações químicas do polímero, mesmo sem oxigênio. Isto teria a possibilidade de diminuir o impacto ambiental do lixo.


Capa do Applied and Environmental Microbiology e imagem do fungo de planta amazônica
Leia o restante desse texto »
20 de fevereiro de 2012
Por: Paulo Yokota | Seção: Cultura, Editoriais, Notícias, webtown | Tags: artigo na Folha de S.Paulo, esforços científicos em diversas instituições, laboratórios da Toyota, pesquisas da Embrapa
A Folha de S.Paulo. em sua edição de 18 de fevereiro, sábado, noticiou com um artigo de Giuliana Miranda ,enviada a Vancouver, no Canadá, que os cientistas buscam melhorar a fotossíntese das plantas, que representaria uma nova Revolução Verde, aumentando a capacidade de transformação da energia solar em outras formas de energia. Segundo ela, uma das palestras proferidas na AAAS – Sociedade Americana para o Progresso da Ciência, em Vancouver, Canadá, sobre o assunto teria despertado grande interesse.
A palestra foi proferida pela Anna Jones, da Universidade do Estado de Arizona. O artigo explica que otimizar o processo de transformação da energia solar pela fotossíntese permitiria melhorar culturas de alimentos e combustíveis renováveis de forma sustentável em grande quantidade. Segundo Anna Jones, a enzima que acelera a fotossíntese, a rubisco, acaba saturando depois de algum tempo de exposição. Para melhorar o processo, os cientistas estão desenvolvendo diversos processos, como pensar o assunto como uma bateria.

Gráfico publicado na Folha de S.Paulo no dia 18/02/2011
Leia o restante desse texto »
20 de fevereiro de 2012
Por: Paulo Yokota | Seção: Cultura, Editoriais, Notícias, webtown | Tags: Antonio Donato Nobre do Inpe, apresentações científicas e políticas, Folha de S.Paulo | 2 Comentários »
Segundo a Folha de S.Paulo, na sua seção de ciência, Antonio Donato Nobre, cientista do INPE – Instituto Nacional de Pesquisas Espaciais, informa que foi desenvolvido o sistema denominado Hand, simples que permite as previsões de enchentes e outros desastres naturais. Ele integra informações topográficas, o Google Earth e a matemática para calcular áreas de risco de enchentes, deslizamentos e outros desastres naturais.
O trabalho já teria sido apresentado em congressos científicos tendo sido publicado pelo prestigioso “Journal of Hydrology”, despertando interesse pela sua simplicidade. Também foi apresentado no Senado Federal e na Câmara dos Deputados do Brasil, tendo sido elogiado pelos políticos, mas nenhuma medida prática foi tomada para a sua utilização.


Antonio Donato Nobre e o ministro Marco Antonio Raupp
Leia o restante desse texto »
16 de fevereiro de 2012
Por: Paulo Yokota | Seção: Cultura, Editoriais, Notícias, webtown | Tags: incenso de Iwaji, longa história, publicado no Highlighting Japan, um artigo do Gavin Blair
Todos conhecem os incensos populares que são utilizados em todo o mundo, principalmente nos países asiáticos como a Índia, mas os produzidos em Iwaji, na prefeitura de Hyogo, no Japão, têm uma tradição peculiar, com qualidade excepcional, sendo um pouco mais caros. O artigo de Gavin Blair, um jornalista que vive em Tóquio, traz uma história interessante para o Highlighting Japan para informar que há 1.600 anos, no século VI, uma tora de madeira foi achada na praia da Ilha de Iwaji. Os vilarejos queimaram a mesma e notaram o agradável aroma que se espalhou pela ilha.
Em 1850, um comerciante notou a potencialidade da produção de incenso fabricado na ilha, beneficiado pelo forte vento oeste que permite que o mesmo seja seco. O porto permite a chegada das matérias-primas e a colocação dos produtos nos mercados, e a história desta companhia Keigado já se estende por dois séculos.

1) diferentes tipos de madeira e conchas que servem de matéria-prima; 2) blocos de incenso que são transformados em palitos; 3) idosa que junta os incensos com a sua marca; 4) um incenso na entrada do Keigado. Fotos: Jeremy Sutton-Hibbert
Leia o restante desse texto »
14 de fevereiro de 2012
Por: Paulo Yokota | Seção: Cultura, Editoriais, Notícias, webtown | Tags: número de fevereiro, os serviços japoneses, publicação mensal do Governo do Japão
 Ainda que muitas pessoas tenham resistências ideológicas pelas iniciativas governamentais em áreas que podem ser cobertas pelo setor privado, há que se admitir que o pouco que o Japão faz oficialmente na parte cultural está bem enfocada, atualizada e concisa na sua revista online Highlighting. De leitura agradável e interessante, não dá aquela impressão que os brasileiros costumam chamar de “chapa branca” e pode ser acessada facilmente pelo:
Ainda que muitas pessoas tenham resistências ideológicas pelas iniciativas governamentais em áreas que podem ser cobertas pelo setor privado, há que se admitir que o pouco que o Japão faz oficialmente na parte cultural está bem enfocada, atualizada e concisa na sua revista online Highlighting. De leitura agradável e interessante, não dá aquela impressão que os brasileiros costumam chamar de “chapa branca” e pode ser acessada facilmente pelo:
http://www.gov-online.go.jp/eng/publicity/book/hlj/index.html
No número deste mês de fevereiro de 2012, o seu artigo de capa bem como a maioria do seu conteúdo, refere-se aos serviços japoneses muito apreciados pelos estrangeiros, tendo o título “At Your Service”.
Leia o restante desse texto »
8 de fevereiro de 2012
Por: Paulo Yokota | Seção: Cultura, Editoriais, Notícias, webtown | Tags: artigo de Matthew Larking no The Japan Times, exposição de Nobuya Hoki, o nihonga e o mangá
Segundo o autor Matthew Larking, o artigo publicado no The Japan Times sobre o trabalho do artista Nobuya Hoki oscila entre duas tendências principais da arte contemporânea japonesa. De um lado, a recuperação do Nihonga, o estilo japonês de pintura, e o popular mangá que se tornou conhecido em todo o mundo, como o desenho animado japonês.
O estilo do artista Nobuya Hoki é muito particular, pois ele trabalha com dois pincéis criando o que ficou conhecido como “pintura de linha dupla”, e o seu mangá é de uma tendência completamente infantil, abstrato suficiente para obscurecer qualquer narrativa especificamente.

Leia o restante desse texto »
3 de fevereiro de 2012
Por: Paulo Yokota | Seção: Cultura, Editoriais, Notícias, webtown | Tags: criatividade na escassez, da University of Southern California, entrevista da Rachel Will, US-China Today | 2 Comentários »
Uma interessante entrevista feita por Rachel Will com Sasha Gong foi publicada no US-CHINA TODAY, da University of Southern California, sobre o livro que o entrevistado preparou junto com Scott Seligmann, sobre a culinária chinesa utilizando a criatividade no período de escassez da Revolução Cultural.
O entrevistado que era de Guangzhou, na região cantonesa, que apresenta a culinária chinesa mais conhecida no mundo, foi obrigado com sua família a trabalhar numa pequena vila na província de Hunan. Aprendeu a utilizar a sua criatividade e conhecimento para cozinhar com o que estava disponível, e o livro trata de pratos que podem ser preparados com o que se encontra em qualquer parte dos Estados Unidos, não necessitando de ingredientes só possíveis de serem conseguidas em estabelecimentos especializados.


Leia o restante desse texto »
2 de fevereiro de 2012
Por: Paulo Yokota | Seção: Cultura, Editoriais, Notícias, webtown | Tags: agora o de Habin na China, competição dos festivais de inverno, o tradicional de Sapporo em Hokkaido
Por: Paulo Yokota Seção: Cultura, Editoriais e Notícias, WebTown Tags:
Uma saudável competição entre festivais de inverno na Ásia estão atraindo as atenções mundiais, visando aproveitar este período de inverno rigoroso na China e no Japão, para promoverem o turismo. O mais tradicional era o de Sapporo, em Hokkaido, mas agora Harbin, no Norte da China, entra com todo o seu esforço para impressionar os potenciais turistas.


Esculturas de gelo em Sapporo

Esculturas em Harbin, com luzes fluorescentes. Foto: Jonathan Browning
Outras fotos podem ser encontradas no Google Images Winter Festival Sapporo 2012 e as de Johathan Browing, que é um fotografo freelancer sediado em Xangai, na China, entrando no:
http://www.foreignpolicy.com/articles/2012/02/01/china_ice_festival_photos#5
31 de janeiro de 2012
Por: Paulo Yokota | Seção: Cultura, Editoriais, Notícias, webtown | Tags: empenham-se com os brasileiros no Japão, grupo de atores japoneses de Tokyo, visitaram o Brasil | 4 Comentários »
Ainda que seja natural em qualquer país que a média da população conheça pouco do exterior, os analistas se surpreendem quão pouco japoneses sabem sobre seus imigrantes no Brasil. Uma parte disto decorre da tentativa de esquecer que o Japão já passou por situação tão difícil que teve que enviar para o exterior parte de sua população que não conseguia se sustentar no país, como os que emigraram para países como o Brasil. No artigo publicado no The Japan Times, Mami Maruko descreve um grupo denominado Mari Mari que se empenha agora a difundir a cultura popular japonesa no exterior, citando o trabalho desenvolvido no Brasil, de uma forma um tanto romântica.
Eles procuram divulgar para os descendentes de japoneses parte da cultura nipônica, ainda que de forma rudimentar. Apoiado pela Universidade de Shizuoka de Arte e Cultura, Hotaka Hagiwara, líder de um grupo, viajou para o Brasil com outro membro do grupo, Masakazu Teramoto, apresentando contos japoneses em diversas instituições no Estado de São Paulo.


Fotos da trupe Mari Mari publicadas no Japan Times
Leia o restante desse texto »